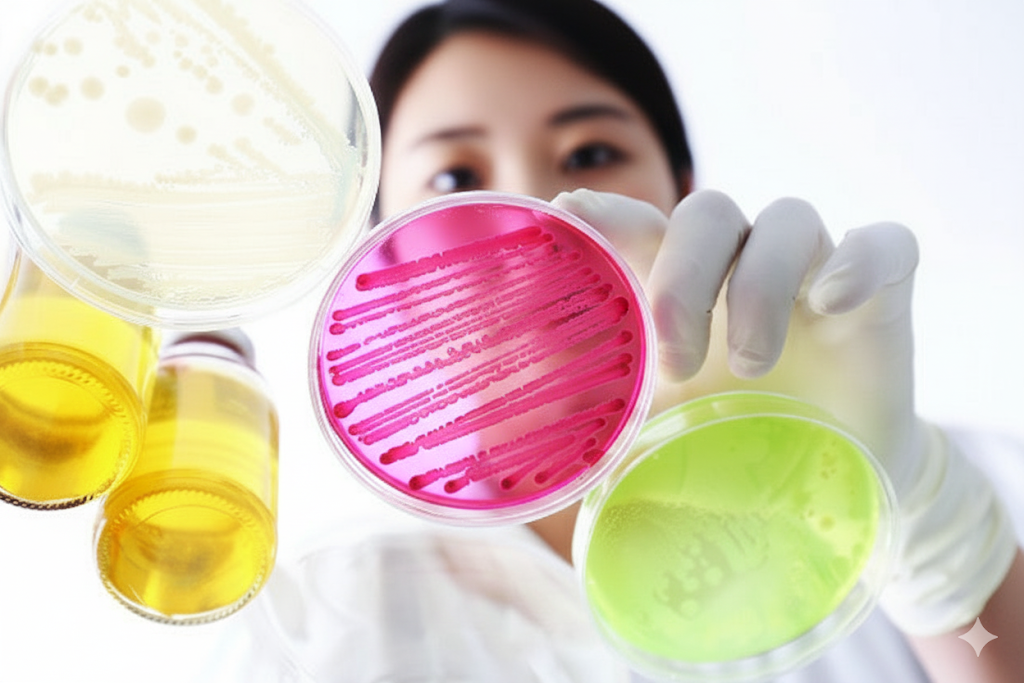

슈퍼 박테리아 CRE, 올바른 이해와 예방법 (2025 최신)
(30대 가장을 위한 우리 가족 건강 지킴이 가이드)
언론에서 '슈퍼 박테리아'라는 단어를 들으면, 막연한 두려움부터 앞서는 것이 사실입니다. 특히 최근 병원 내 감염 사례로 자주 언급되는 **CRE(카바페넴 내성 장내세균속균종)**는 마치 보이지 않는 공포처럼 다가오기도 합니다. 하지만 지피지기면 백전백승이라 했습니다.
이 글은 CRE에 대한 막연한 공포를 '이성적인 이해'로 바꾸기 위해 작성되었습니다. CRE는 결코 미지의 괴물이 아니며, 그 정체를 정확히 알고 올바른 생활 습관을 갖춘다면 충분히 예방할 수 있는 문제입니다.
CRE의 정체부터 전파 경로, 그리고 우리 가족을 지키는 가장 확실한 예방법까지, 30대 가장의 눈높이에서 명쾌하게 정리했습니다. 부디 이 글이 독자 여러분의 건강한 삶을 지키는 든든한 방패가 되기를 바랍니다.
"CRE는 막연한 두려움의 대상이 아니라,
올바른 지식과 생활 속 작은 습관으로 충분히 예방할 수 있는 문제입니다."
1. '슈퍼 박테리아' CRE, 그 정체는 무엇인가?
CRE는 **'카바페넴 내성 장내세균속균종(Carbapenem-Resistant Enterobacteriaceae)'**의 약자입니다. 말이 어렵지만, 풀어보면 간단합니다. '카바페넴'이라는 **가장 강력한 항생제**에도 내성이 생겨 죽지 않는 **장내세균**이라는 뜻입니다. 즉, 최후의 보루로 여겨지는 항생제까지 무력화시키는 독한 놈이라 '슈퍼 박테리아'라고 불리는 것입니다.
핵심 포인트: 건강한 사람에게는 무해하다?
CRE는 건강한 사람의 장 속에 살면서 아무런 증상도 일으키지 않는 경우가 대부분입니다. 문제는 **면역력이 약해진 사람**의 몸속(혈액, 폐 등)으로 침투했을 때입니다. 이때 요로 감염, 폐렴, 패혈증 등 다양한 감염병을 일으키고, 치료할 항생제가 마땅치 않아 매우 위험해질 수 있습니다.
2. 전파 경로와 고위험군: 공포는 금물, 팩트 체크가 우선
가장 중요한 사실부터 말씀드리겠습니다. CRE는 기침이나 재채기 등 **공기를 통해 전염되지 않습니다.** 따라서 일상적인 생활 공간에서 감염될 확률은 매우 낮습니다.
(1) 주요 감염 경로
CRE는 주로 감염자와의 **직접적인 접촉**이나, 균에 **오염된 환경(의료 기구, 주변 환경 등)**을 통해 전파됩니다. 이것이 병원이나 요양병원 같은 의료기관에서 감염 관리가 특히 중요한 이유입니다.
(2) 고위험군은 누구인가?
CRE는 건강한 일반인에게는 큰 위협이 되지 않습니다. 하지만 아래와 같은 **고위험군**에게는 치명적일 수 있습니다.
- 장기간 병원에 입원 중인 환자
- 항생제를 장기간 투여했거나, 수술 등 침습적 시술을 받은 환자
- 만성 질환(당뇨병, 암 등)으로 면역력이 약해진 사람
- 중환자실에 입원한 경험이 있는 사람
3. 최고의 백신, '올바른 손 씻기'의 모든 것

CRE를 포함한 모든 감염병을 예방하는 가장 간단하고도 강력한 방법은 바로 **'올바른 손 씻기'**입니다. 이는 아무리 강조해도 지나치지 않습니다.
질병관리청이 권고하는 '올바른 손 씻기 6단계'
- 1단계: 손바닥과 손바닥을 마주 대고 문질러 줍니다.
- 2단계: 손등과 손바닥을 마주 대고 문질러 줍니다.
- 3단계: 손바닥을 마주 대고 손깍지를 끼고 문질러 줍니다.
- 4단계: 손가락을 마주 잡고 문질러 줍니다.
- 5단계: 엄지손가락을 다른 편 손바닥으로 돌려주며 문질러 줍니다.
- 6단계: 손톱 밑을 반대편 손바닥에 놓고 문지르며 씻어냅니다.
이 모든 과정을 **흐르는 물과 비누**를 이용해 **30초 이상** 실천해야 합니다. 손 소독제는 비누와 물을 사용할 수 없는 상황에서의 보조 수단임을 기억하십시오.
4. 진짜 적은 따로 있다: '항생제 오남용'의 위험성
슈퍼 박테리아가 탄생한 근본적인 원인은 바로 **'항생제 오남용'**입니다. 필요하지 않은데도 항생제를 복용하는 습관이 세균에게 내성을 기를 시간을 주는 셈입니다.
우리가 지켜야 할 항생제 사용 원칙
- 감기에는 항생제가 필요 없습니다: 감기는 '바이러스'가 원인입니다. 항생제는 '세균'을 죽이는 약이므로, 바이러스성 질환인 감기에는 아무런 효과가 없습니다.
- 의사의 처방을 끝까지 따르십시오: 증상이 나아졌다고 해서 임의로 항생제 복용을 중단하면, 살아남은 일부 세균이 내성을 갖게 될 수 있습니다. 처방받은 기간과 용량을 반드시 끝까지 지켜야 합니다.
- 남은 항생제를 보관하거나 나눠 먹지 마십시오.

5. 우리 아이와 가족을 위한 CRE 예방법 Q&A
Q1. 건강한 우리 아이, CRE에 감염될 수 있나요?
A1. 가능성은 매우 낮습니다. 앞서 설명드렸듯이, CRE는 주로 면역력이 크게 저하된 환자에게서 문제를 일으킵니다. 건강한 아이가 일상생활에서 CRE에 감염될 위험은 거의 없으므로, 과도한 걱정은 하지 않으셔도 됩니다.
Q2. 아이가 감기에 걸렸는데, 항생제 처방을 요구해도 될까요?
A2. 절대 안 됩니다. 아이가 아플 때 현명하게 대처하는 것이 중요합니다. 항생제는 꼭 필요한 세균성 질환(예: 세균성 폐렴, 중이염 등)에만 사용해야 합니다. 의사의 진료와 판단을 신뢰하고, 불필요한 항생제 처방을 요구하지 않는 것이 우리 아이와 사회 전체를 위한 길입니다.
Q3. 가족의 병문안을 다녀왔는데, 특별히 조심해야 할까요?
A3. 네, 그렇습니다. 의료기관 방문 후에는 더욱 철저한 위생 관리가 필요합니다. 귀가 즉시 외투를 털고, 비누를 이용해 꼼꼼하게 손을 씻는 습관을 들여야 합니다. 입원 환자의 보호자나 간병인이라면, 환자와 접촉하기 전과 후에 반드시 손을 소독해야 합니다.
마무리하며: 슈퍼 박테리아 CRE는 무분별한 항생제 사용으로 인해 우리 스스로가 만들어낸 문제입니다.
막연한 두려움을 갖기보다는, 그 정체를 올바르게 이해하고
'올바른 손 씻기'와 '현명한 항생제 사용'이라는 기본 원칙을 생활화하는 것만이
나와 우리 가족을 지키는 가장 확실한 방법임을 기억해야 합니다.